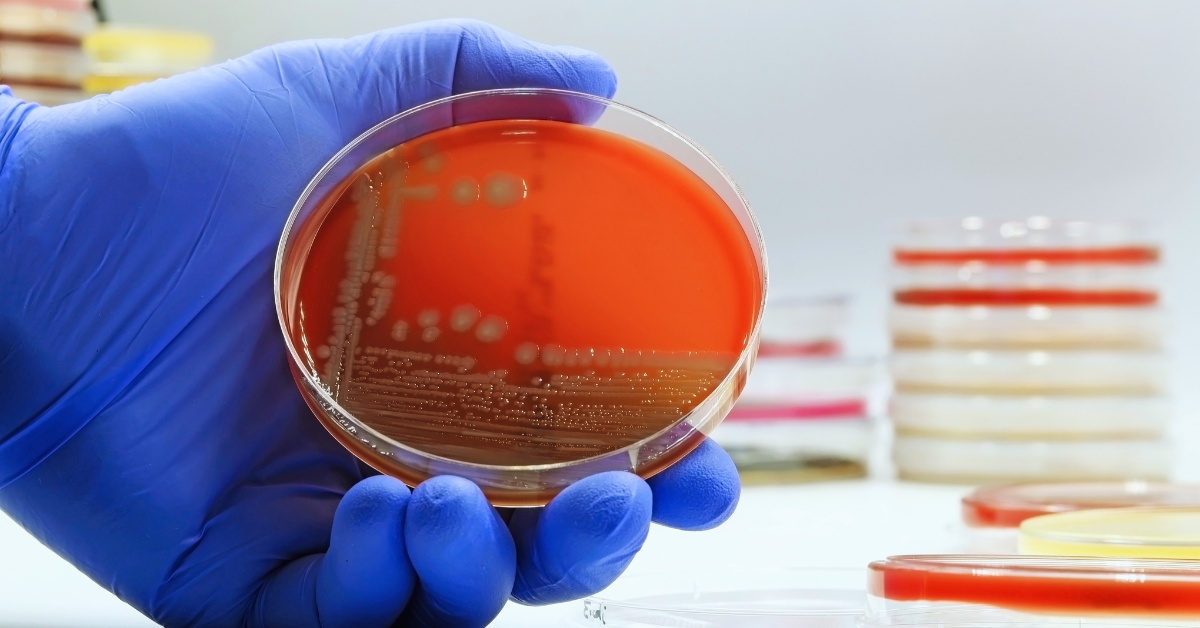
Tubig sa ilang poso sa Los Baños kontaminado ng E. coli — pag-aaral ng UPLB

Tubig sa ilang poso sa Los Baños kontaminado ng E. coli — pag-aaral ng UPLB
Margret Dianne Fermin • Ipinost noong 2025-11-13 08:53:36
Los Baños, Laguna — Isang pag-aaral ng mga student researchers mula sa University of the Philippines Los Baños (UPLB) ang nagbunyag ng presensya ng Escherichia coli (E. coli) sa ilang sample ng tubig mula sa mga artesian well o poso sa tatlong barangay sa Los Baños, Laguna.
Ayon sa ulat ng UPLB na isinapubliko noong Nobyembre 12, sinuri ng mga estudyante ang tubig mula sa tig-10 poso sa Barangays Bayog, Mayondon, at Malinta. Natuklasan nila ang mga E. coli isolates sa ilang sample, na indikasyon ng posibleng fecal contamination sa mga pinagkukunan ng tubig.
“The said samples were collected from 10 artesian well pumps each in Barangays Bayog, Mayondon, and Malinta,” ayon sa ulat ng ABS-CBN News.
Ang E. coli ay isang uri ng bakterya na karaniwang matatagpuan sa bituka ng tao at hayop, ngunit ang ilang strain nito ay maaaring magdulot ng sakit kapag napunta sa inuming tubig. Ayon sa mga eksperto, ang kontaminasyon ay maaaring dulot ng hindi maayos na septic systems, pagtagas mula sa mga kanal, o kawalan ng regular na water treatment.
Dagdag pa sa ulat ng UP Office of the Vice President for Academic Affairs, maraming residente sa mga rural na bahagi ng Los Baños ang umaasa sa poso bilang pangunahing pinagkukunan ng tubig dahil sa mataas na presyo o limitadong access sa commercial potable water.
Isang hiwalay na pag-aaral na inilathala sa Philippine Journal of Science ang nagsiwalat na ang ilang E. coli strains mula sa mga poso ay multidrug-resistant, na nangangahulugang hindi basta-basta tinatablan ng karaniwang antibiotics. Ito ay nagdudulot ng mas mataas na panganib sa kalusugan, lalo na sa mga bata at matatanda.
Bilang tugon, nanawagan ang mga mananaliksik sa lokal na pamahalaan ng Los Baños at mga ahensyang pangkalusugan na magsagawa ng mas malawak na water quality testing at magpatupad ng mga hakbang upang matiyak ang kaligtasan ng inuming tubig sa mga komunidad.
